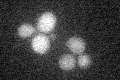
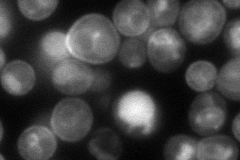
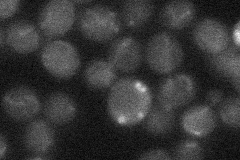
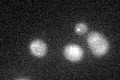

View description
Maltose permease, high-affinity maltose transporter (alpha-glucoside transporter); encoded in the MAL3 complex locus; member of the 12 transmembrane domain superfamily of sugar transporters; functional in genomic reference strain S288C
Localization:
Intensity:
Fold change:
Significance:
-
C’ GFP library in SD
below threshold15.18 -
N' NOP1pr-GFP in SD
cell periphery,ER104.001 -
N' TEF2pr-mCherry in SD

cell periphery,vacuole164.009 -
N' NATIVEpr-GFP in SD
below threshold19.1864 -
N' TEF2pr-VC and Cyto-VN in SD

punctate,vacuole membrane40.9768 -
C’ GFP library in SD+DTT
cytosol13.980.92No -
C’ GFP library in SD+H2O2

cytosol15.511.02No -
C’ GFP library in Starvation Media

cytosol15.691.03No -
C’ GFP library on the background of Pup2-DaMP

below threshold -
C’ GFP library on the background of CCT mutant

below threshold14.92010.982203No
